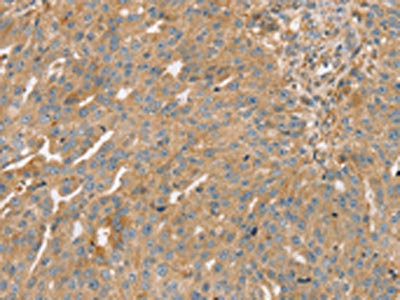

STX16 Antibody
-
中文名稱:STX16兔多克隆抗體
-
貨號:CSB-PA794673
-
規格:¥1100
-
圖片:
-
The image on the left is immunohistochemistry of paraffin-embedded Human esophagus cancer tissue using CSB-PA794673(STX16 Antibody) at dilution 1/30, on the right is treated with fusion protein. (Original magnification: ×200)
-
The image on the left is immunohistochemistry of paraffin-embedded Human breast cancer tissue using CSB-PA794673(STX16 Antibody) at dilution 1/30, on the right is treated with fusion protein. (Original magnification: ×200)
-
Gel: 8%SDS-PAGE, Lysate: 40 μg, Lane 1-3: MCF7 cells, A172 cells, hepg2 cells, Primary antibody: CSB-PA794673(STX16 Antibody) at dilution 1/400, Secondary antibody: Goat anti rabbit IgG at 1/8000 dilution, Exposure time: 5 seconds
-
-
其他:
產品詳情
-
Uniprot No.:
-
基因名:STX16
-
別名:STX16; Syntaxin-16; Syn16
-
宿主:Rabbit
-
反應種屬:Human,Mouse
-
免疫原:Fusion protein of Human STX16
-
免疫原種屬:Homo sapiens (Human)
-
標記方式:Non-conjugated
-
抗體亞型:IgG
-
純化方式:Antigen affinity purification
-
濃度:It differs from different batches. Please contact us to confirm it.
-
保存緩沖液:-20°C, pH7.4 PBS, 0.05% NaN3, 40% Glycerol
-
產品提供形式:Liquid
-
應用范圍:ELISA,WB,IHC
-
推薦稀釋比:
Application Recommended Dilution ELISA 1:2000-1:5000 WB 1:500-1:2000 IHC 1:25-1:100 -
Protocols:
-
儲存條件:Upon receipt, store at -20°C or -80°C. Avoid repeated freeze.
-
貨期:Basically, we can dispatch the products out in 1-3 working days after receiving your orders. Delivery time maybe differs from different purchasing way or location, please kindly consult your local distributors for specific delivery time.
-
用途:For Research Use Only. Not for use in diagnostic or therapeutic procedures.
相關產品
靶點詳情
-
功能:SNARE involved in vesicular transport from the late endosomes to the trans-Golgi network.
-
基因功能參考文獻:
- we here present a patient with PHP1b caused by a recurrent STX16 deletion, presenting with macrosomia, early onset obesity, and macrocephaly without other AHO symptoms. we reemphasize STX16 deletions and PHP1b as a rare cause for early onset obesity and macrosomia. PMID: 27338644
- STX16 microdeletion was identified in male monozygotic twins (with pseudohypoparathyroidism type 1B leading to growth hormone deficiency) and mother/grandmother (not father/grandfather or sister [their triplet with separate placenta]). [CASE STUDY] PMID: 25843330
- syntaxin 16 is a key regulator of cytokinesis. PMID: 24109596
- A patient with familial pseudohypoparathyroidism type Ib and his asymptomatic brother were found to have methylation defect at GNAS (guanine nucleotide-binding protein G) and microdeletion involving exons 4-6 of neighboring gene STX16. [CASE REPORT] PMID: 23095209
- De novo 3-kb STX16 deletions, reported only once previously, are infrequent but should be excluded in all cases of Pseudohypoparathyroidism-Ib, even when the family history is negative for an inherited form of this disorder. PMID: 23087324
- Results suggest that STX16 mediates recycling of CFTR and constitutes an important component of CFTR trafficking machinery in intestinal epithelial cells. PMID: 20826815
- the region of overlap between the two microdeletions likely harbors a cis-acting imprinting control element that is necessary for establishing and methylation at GNAS exon A/B, thus allowing normal G alpha(s) expression in the proximal renal tubules. I PMID: 15800843
- function of syntaxin 16 was specifically required for, and restricted to, the retrograde pathway PMID: 17389686
- Syntaxin 16 may thus play a role in neurite outgrowth and perhaps other specific dendritic anterograde/retrograde traffic. PMID: 17852734
- phosphorylation of RASSF1A by Aurora B is required for the recruitment of Syntaxin16 PMID: 19887622
顯示更多
收起更多
-
相關疾病:Pseudohypoparathyroidism 1B (PHP1B)
-
亞細胞定位:Golgi apparatus membrane; Single-pass type IV membrane protein.; [Isoform C]: Cytoplasm.
-
蛋白家族:Syntaxin family
-
組織特異性:Ubiquitous.
-
數據庫鏈接:
Most popular with customers
-
-
YWHAB Recombinant Monoclonal Antibody
Applications: ELISA, WB, IHC, IF, FC
Species Reactivity: Human, Mouse, Rat
-
Phospho-YAP1 (S127) Recombinant Monoclonal Antibody
Applications: ELISA, WB, IHC
Species Reactivity: Human
-
-
-
-
-